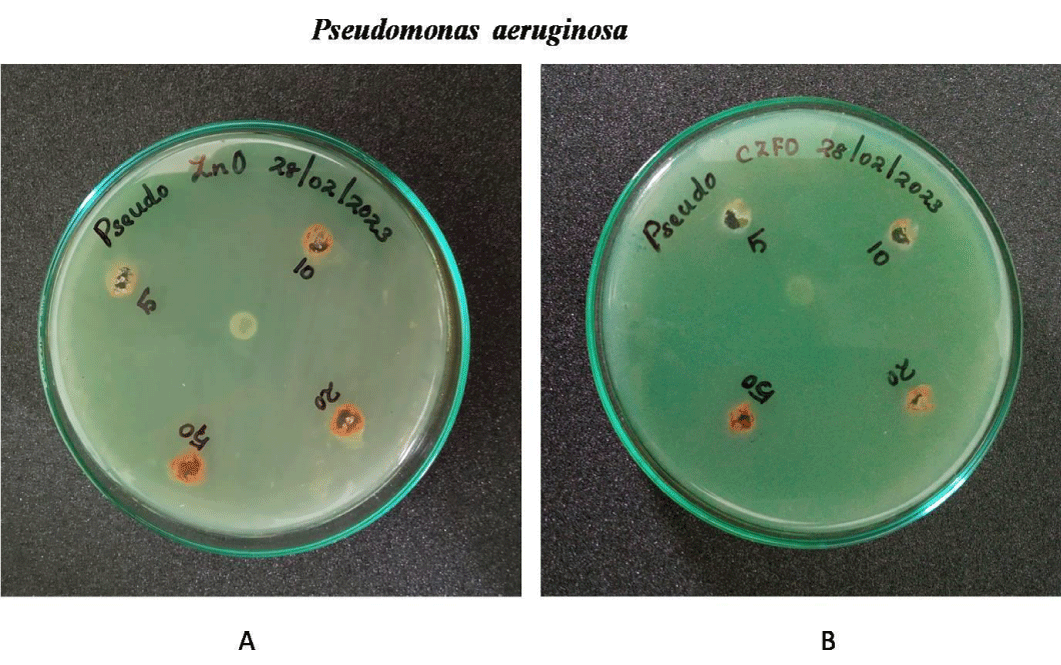
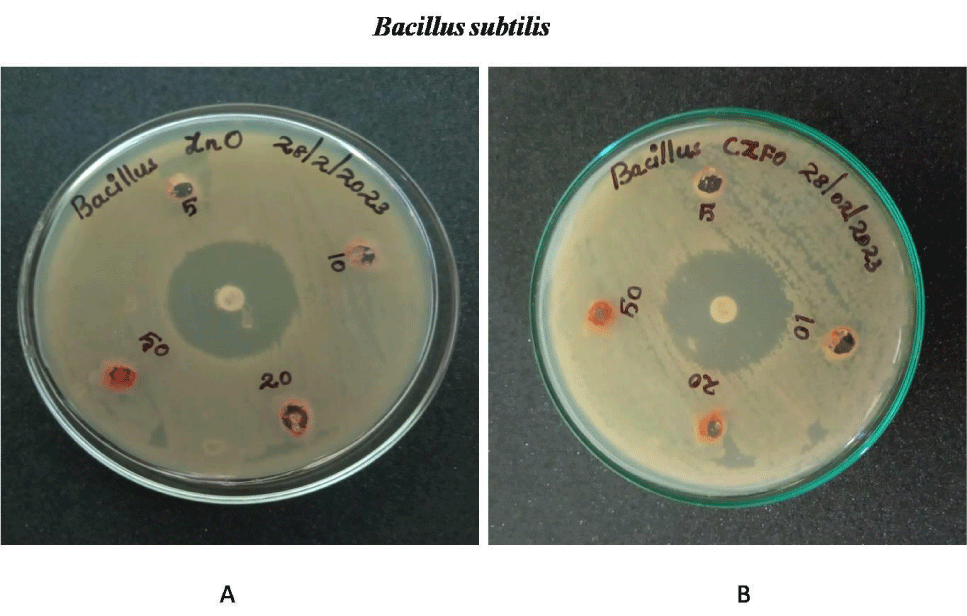
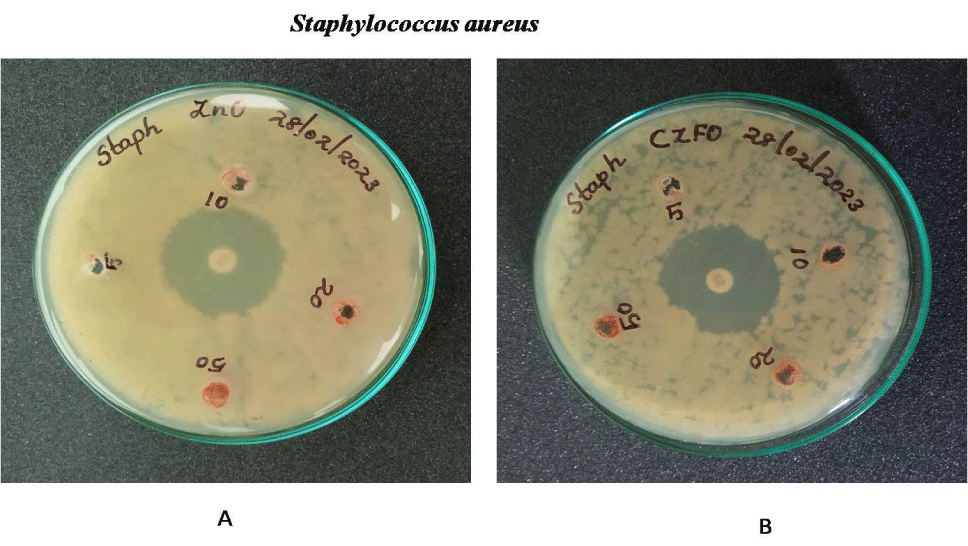
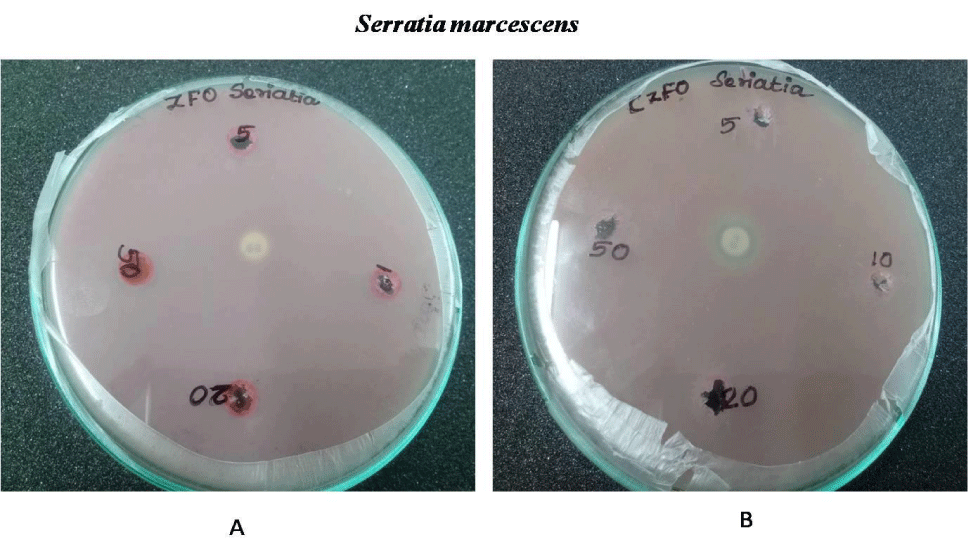
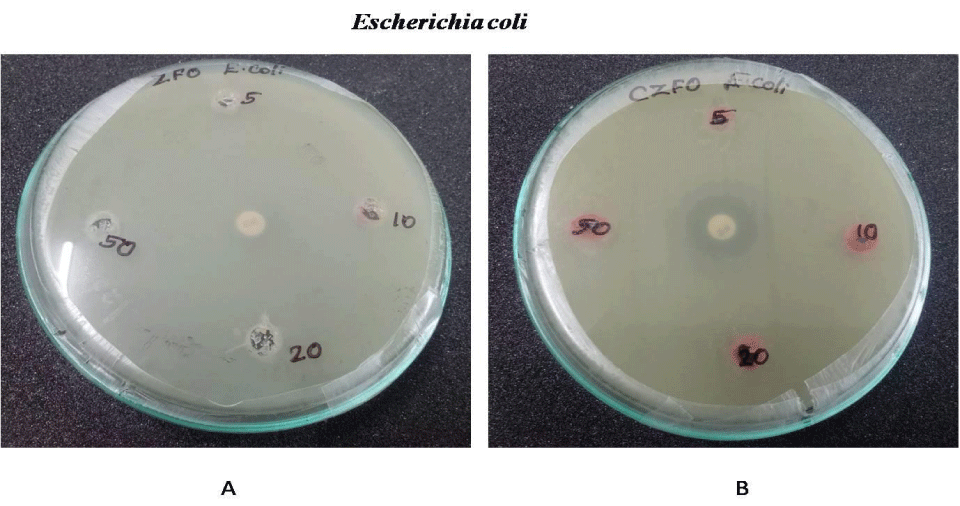

Biology Group. 2024 August 31;5(8):1046-1056. doi: 10.37871/jbres1986.
Cytotoxicity and Antibacterial Assessment of Zinc Ferrite and Cobalt Zinc Ferrite Nanoparticles with Siha, H9c2 and Hek 293 Cells
Leena Grace Beslin* and Arya AR
- Cancer
- Cells
- Carcinogens
- Nanoparticles and treatment
Abstract
The fast growing medical techniques and advances in medication system is very reliable for focusing targets according to their capability against different hallmarks. There is validation of particular activity to know whether it is effective against biology of cancer cells or not, if so then it should impair cancer growth and progression on its inhibition. The ferrite Nanoparticles (NPs) are the growing research area for biomedical applications. When Ferrite NPs interacts with any trivalent ion, cation, the spinel ferrite having chemical formula MFe2O4 (divalent cation) shows the category of the ferrite material. The ferrite materials have both ferromagnetic and semiconductor properties. In the present study we evaluated the anticancer and antibacterial property of zinc ferrite and cobalt zinc ferrite nanoparticles. Cytotoxicity of zinc ferrite and cobalt zinc ferrite was tested on uterine cancer cells (SiHa) which didn’t show a significant cytotoxicity at 5, 10, 20 and 50 µg/ml. This was evident from the results of neutral red assay and MTT assay. Treatment of H9c2 cells with zinc ferrite and cobalt zinc ferrite also showed the same result that the cell viability was not affected but cell morphology was altered at higher concentrations. The cytotoxic effect of Zinc ferrite and cobalt zinc ferrite was also analyzed in Human Embryonic Kidney cells (HEK 293 cells). All the tested concentrations didn’t affect the viability of HEK 293 cells. The present study also compared the antibacterial property of both ZFO and CZFO. Both compounds didn’t show antibacterial activity against both gram positive and negative bacteria.
Introduction
Cancer is the second leading cause of mortality worldwide. Overall, the prevalence of cancer has been increased worldwide. Most commonly men are affected at high rate of prostate, lung and bronchus, colon and rectum, and urinary bladder cancer respectively. In women, cancer prevalence is highest in the breast, lung and bronchus, colon and rectum, uterine corpus and thyroid, respectively. Cancer occurs by a series of successive mutations in genes so that these mutations change cell functions. Environmental chemical substances with carcinogenic properties influence directly or indirectly the cytoplasm and nucleus of cells, and lead to genetic disorders and gene mutations. Viruses, bacteria and radiation rays are other carcinogenesis factors, comprising about 7% of all cancers [1].
Proto-oncogenes are responsible for cell division and growth under normal condition, but become oncogenes during genetic mutation, which are most dangerous for cell existence leading to abnormal cell division. Genetic changes that lead to oncogene generation and genetic disorders include chromosomal translocation (gene Bcr and oncogene Abl in chronic blood cancer), point mutation (Ras gene in colon cancer), deletion (Erb-B gene in breast cancer), amplification (N-myc in neuroblastoma), and insertion activation (C-myc in acute blood cancer).
Major risk factors involved in cancer progression are tobacco, alcohol, diet, obesity, infectious agents, environmental pollution and radiation. Only 5-10% of all cancer cases are due to genetic defects and the remaining 90-95% is due to environment and lifestyle. Because tobacco, diet, infection, obesity, and other factors contribute approximately 25-30%, 300-35%, 15-20%, 10-20%, and 10-15%, respectively. Almost 90% of patients diagnosed with lung cancer are cigarette smokers. Infection by various bacteria and viruses is another very prominent cause of various cancers. Diet, obesity, and metabolic syndrome are very much linked to various cancers and may account for as much as 30-35% of cancer deaths, indicating that a reasonably good fraction of cancer deaths can be prevented by modifying the diet [2].
Targeted therapies for the treatment of tumor have proven fruitful in the past three decades. These are solely mechanism based therapies for targeting human cancer and have shown effectiveness in possessing therapeutic efficacy against human cancer. The therapies that are not fully developed or under clinical trial phase are not considered for the treatment purpose. Specific molecular targets are engaged in a way or other way to enable specific capabilities that are directed towards specified molecular targets. Growing experimental proofs from interpretation of history states that the capabilities of hallmarks are partially regulated by signaling pathways [3]. Consequently, when there is inhibition of main pathway of tumor by targeted therapeutics, it is not mandatory that it completely wave off the capability of hallmark and resulting in survival of few tumor cells to survive till they are not burden under pressure enforced by cancer therapy. Renewed cancer growth, clinical relapse and functional capabilities can be achieved by mutation, remodeling microenvironment of stromal cells and epigenetic reprogramming. There is still scope of establishment of applicability to human tumors. It can be easily understood from an example that there are deployments in drugs that induce apoptosis that are responsible for inducing cancerous cells to a hyperactive signaling of mitogenic cells that have authority to compensate the trigger from prior attrition rate during the treatment. Significant advancement in a better understanding of the metastasis and invasion process in the malignant growth of tumors can be described more accurately in the near future [4].
Cancer nanomedicine is an advancing field that employs nanoparticles to diagnose and treat cancer. The nanoparticles are capable of delivering the insoluble drugs to local and distant tumor sites effectively by reducing the systemic side effects that are generally associated with conventional drug therapies. These nanodrugs are biocompatible, non-immunogenic, non-toxic, and biodegradable, which in turn reduces the risk of loss of function or adverse effects of cancer treatments [5]. Zinc ferrite is a kind of an important absorbing material because of its high magnetic loss [6].There are also scattered reports on the preparation of zinc ferrite nanoparticles showing photoluminescence or ferromagnetism [7]. Zinc ferrite has several merits such as corrosion, resistivity, chemical stability, superior magnetic properties and low cost. Bulk zinc ferrite has a normal spinel structure with tetrahedral (A) sites occupied by Zn2+ and Fe3+ occupied by octahedral (B) sites, respectively, in oxygen lattice, while nanocrystalline zinc ferrite have a mixed spinel structure with metal ions over any of the A and B sites [8]. Nanosized ZnFe2O4 exhibits remarkable magnetic properties compared to their bulk form.
Several methods have been adopted to synthesize ZnFe2O4 nanoparticles such as sol–gel auto combustion, hydrothermal, molten salt and solvothermal method. Zinc ferrite nanoparticles show potential applications in the field of drug delivery, sensing applications, magnetic resonance imaging and antibacterial [9]. Rapidly quenched zinc iron oxides with nominal compositions of x ZnO (100-x) Fe2O3 where x = 50, 55, 60, 65 and 70 (mol%) were prepared by using a twin-roller quenching method. X-ray diffraction analyses indicate that the most predominant phases precipitated in all the as-quenched specimens are zinc ferrites with spinel structure. The lattice parameters of rapidly quenched zinc ferrites are slightly smaller than that of normal spinel ZnFe2O4 [10].
The magnetization of quenched 60ZnO·40Fe2O3 is 23.8 emu g−1 at room temperature when the external magnetic field is 10 koe. This value is much higher than the magnetization of ZnFe2O4 prepared by the solid state reaction [11]. Some of the Fe3+ ions occupy tetrahedral sites as well as octahedral sites. Some of Zn2+ ions also occupy octahedral sites in the present rapidly quenched zinc ferrites [12]. This leads to the high magnetization caused by strong super exchange interaction between octahedral and tetrahedral Fe3+ ions, as proposed for ultrafine particles of ZnFe2O4 which show high magnetization even at room temperature [13]. Zn K-edge Extended X-Ray Absorption Fine Structure (EXAFS) measurements support that there exist six-coordinated Zn2+ ions in the present rapidly quenched zinc ferrites. In addition, a solid solution of magnetite which is suggested by the lattice parameters of quenched specimens contributes to the high magnetization as well [14].
Cobalt ferrite is a semi-hard ferrite with the chemical formula of CoFe2O4 (CoO·Fe2O3). The substance can be considered as between soft and hard magnetic material and is usually classified as a semi-hard material. Cobalt-Zinc Ferrite Magnetic Nanoparticles (CZF-MNPs) were prepared in air environment by conventional co-precipitation method using ferric, zinc and cobalt salts with sodium hydroxide, at 80°C of solution temperature, and coated with biocompatible Dimercapto SUCCINIC ACID (DMSA). The morphology of desired nanoparticles was investigated by Transmission Electron Microscopy (TEM) and the average size of bare and coated nanoparticles were about 16 and 40 nm. The structural and crystal phase of CZF-MNPs was determined by X-Ray Diffraction (XRD) and the results confirmed the single phase spinel ferrite formation [15]. Magnetization measurements of samples were performed up to maximum field of 9000 Oe at room temperature with a device Alternating [13]. Gradient Field Magnetometry (AGFM).The average of crystallite size was calculated about 13 nm using Scherer’s formula from the broadening of the most intense peak of 311 [16].
The magnetic characteristics of the ferrites depend on the distribution of cation at octahedral and tetrahedral sites [17]. Ferrite nanoparticles have various biological properties such as antimicrobial and anticancer effects. The anticancer effect of Zinc ferrite and cobalt zinc ferrite and also the antibacterial properties were revealed. The objectives met the experimental focus on cytotoxicity of Zinc ferrite and cobalt zinc ferrite was studied on uterine cancer cells SiHa, normal cells H9c2 and HEK 293 cells In vitro system. Antibacterial potential of Zinc ferrite and cobalt zinc ferrite was studied on both gram positive and gram negative bacterial strains.
Materials and Methods
Preparation of zinc ferrite
Zinc Ferrite nanoparticles were synthesized by a simple precipitation method using polyethylene glycol as the surfactant and water as the solvent. The nitrates of Zn and Fe, viz., Zn (NO3)2•6H2O and Fe (NO3)3•9H2O, were taken in the ratio of 1:2 depending on the desired relative composition of Zn2+ in the ferrite and dissolved in the distilled water. The solution was mixed with polyethylene glycol (PEG, added 3 drops) and the reaction mixture was stirred for one hour. The resultant mixture is added with NaOH and stirred vigorously for 30 min until the pH value reaches 8 and kept in the oven at a temperature of 1000C for 10 hours. The obtained sample was washed many times and kept in the muffle furnace for 3 hours at a temperature of 6000C. After cooling, the sample was again powdered to ensure no lumps were formed [18].
Preparation of cobalt ferrite
Cobalt Ferrite nanoparticles were synthesized by a simple precipitation method using polyethylene glycol as the surfactant and water as the solvent. The nitrates of Co and Fe, viz., Co (NO3)2•6H2O and Fe (NO3)3•9H2O, were taken in the ratio of 1:2 depending on the desired relative composition of Co2+ in the ferrite and dissolved in the distilled water. The solution was mixed with polyethylene glycol (PEG, added 3 drops) and the reaction mixture was stirred for one hour. The resultant mixture is added with NaOH and stirred vigorously for 30 min until the pH value reaches 8 and kept in the oven at a temperature of 1000C for 10 hours. The obtained sample was washed many times and kept in the muffle furnace for 3 hours at a temperature of 6000C. After cooling, the sample was again powdered to ensure no lumps were formed [19].
Preparation of cobalt zinc ferrite
Cobalt Zinc Ferrite is prepared by mixing Cobalt Ferrite and Zinc Ferrite to a ratio of 1:0.5.2.4 Cell Culture: Cells were cultured in DMEM with 10% FBS and 1X antibiotic anti mycotic solution (45 ml plain media, 5 ml fetal bovine serum and 0.5 ml antibiotic solution) in a 37°C in incubator maintained at 5% CO2. On attaining confluency, trypsin was used to detach the cells from the adherent surface. After washing with PBS, cells were incubating with trypsin for 1-3 minutes. Trypsin activity was inhibited by adding FS containing media. Transfer the contents to a new centrifuge tube and centrifuged at 2000 rpm for 2 minutes. The resultant pellets were carefully resuspend in a fresh medium and plated the cells at a required density in a new plate. Number of cells were counted using haemocytometer by trypan blue staining [20,21].
Cell counting using haemocytometer
A 1:1 dilution of the cell suspension in trypan blue (0.4%) was prepared. Approximately 10 µl of cell suspension will be required to charge one chamber of the haemocytometer. Load the hemocytometer after moistening and affixing cover slip to the haemocytometer. Cover slip and hemocytometer are clean and grease-free be ensured (used alcohol to clean). A small volume (approximately 10 µl) of trypan blue cell suspension is transferred to one of the chambers of the hemocytometer by carefully touching the cover slip at its edge with the pipette tip and allowing each chamber to fill by capillary action. View the cells under a microscope at 10x magnification. Focus the microscope on one of the 4 outer squares in the grid. The square should contain 16 smaller squares. Count all the cells in the four 1 mm corner squares [22].
Calculation: Count 4 corner squares and calculate the average. Each large square of the hemocytometer, with cover slip in place, represents a total volume of 0.1 mm3 (1.0 mm X 1.0mm X 0.1 mm) or 10-4 cm3. Since 1 cm3 is equivalent to approximately 1 ml, the total number of cells per ml will be determined using the following calculations: The number of cells per square x 104 = the number of cells/ml of suspension.
MTT assay for toxicity evaluation
3-[4, 5-dimethylthiazol-2-yl]-2, 5 Diphenyl Tetrazolium Bromide (MTT) assay was carried as per previously published protocol [23]. Briefly, 5 × 103 cells were seeded on 96 well plates and incubated in Dulbecco’s Modified Minimal Essential Media (DMEM) supplemented with 10% fetal bovine serum and for 24 h inside CO2 incubator set at 5% CO2 and 37°C temperature. Growth media was replaced with incubation media containing compounds at different concentrations in DMEM. Treated cells were incubated overnight and media was replaced with DMEM containing MTT (5 mg/ml). Cells were incubated for 3-4 h for purple coloured formazan crystal development [24]. These water insoluble crystals were dissolved in DMSO with 10% SDS. Absorbance was read at 570 nm with a microplate reader (Model 680 Biorad, USA) in endpoint mode. Percentage of cytotoxicity was calculated based on the formula
where A0 is absorbance of control well and A1 is the absorbance of sample treated well.
Neutral red assay
The Neutral red assay has been performed in cells to determine the cytotoxicity. Cell was seeded in a plate of 96 wells plate (4 × 103 cells/well) and incubated in Dulbecco’s Modified Minimal Essential Media (DMEM) supplemented with 10% Fetal Bovine Serum(FBS) incubated for 24 h at 37°C in a 5% CO2 incubator to allow cell attachment. Growth media was replaced with incubation media containing compounds at different concentrations in DMEM. Treated cells were incubated overnight and media was replaced with DMEM containing neutral red (40 µg/ml).Cells were incubated for 2 h for the uptake of neutral red by live cells. These water insoluble pink crystals were dissolved in a solvent containing 50%ethanol, 1% glacial acetic acid and 49% H2O.The plate is put on the rolling-shaker for 10 minutes and absorbance is recorded at 570 nm using ELISA plate reader [25]. Percentage of cytotoxicity is calculated based on the formula
where A0 is absorbance of control well and A1 is the absorbance of sample treated well.
Anti-bacterial activity by well diffusion method
Antibacterial activities of the nanocompounds were studied by well diffusion method in nutrient Agar plates. Bacterial cultures of Escherichia coli, Serratia marcescens, Bacillus subtilis, Stephylococcus aereus and Psedomonas aeurginosa were used for the study. About 0.1 ml of each of the prepared liquid culture of bacteria to be tested was loaded on the agar plate. The plates were swabbed uniformly using a sterile swab and allowed to dry for 5 min. Wells (8 mm in diameter) were bored on an inoculated agar plate, and the nanoparticles with concentration were poured into the well and incubated at 37°C for 24 hours. The zone of inhibition was evaluated after 24 Hours [26].
Statistical analysis
All in-vitro experiments were conducted in triplicate and reading in continuous variable were expressed as mean with SEM. Variables with broad range of distribution were transformed logarithmically before analysis.
Results
The present study was designed to assess the cytotoxicity Zinc Ferrite (ZFO) and Cobalt Zinc Ferrite (CZFO) nanoparticles. Along with that we also studied the antibacterial activity of Zinc Ferrite (ZFO) and Cobalt Zinc Ferrite (CZFO) nanoparticles. As nanoparticles increases the effectiveness of drug at lower concentrations and low possible side effects increases the acceptability of nanomedicine in cancer therapy.
Effect of Zinc Ferrite (ZFO) nps and cobalt zinc ferrite on siha cell morphology
The cytotoxic effect of Zinc Ferrite (ZFO) and Cobalt Zinc Ferrite (CZFO) on uterine cancer cells (SiHa) were observed by the morphological changes of SiHa cells under a microscope. Different concentrations (5, 10, 20, 50 µg/ml) of ZFO and CZFO were treated on the cells in culture. After 24 hours of treatment cell morphology was observed. Our study showed that nanoparticles such as Zinc Ferrite (ZFO) and Cobalt Zinc Ferrite (CZFO) were showed variations in SiHa cell morphology. But the number of cells in treated groups didn’t show any significant change in all the tested concentrations (Figures 1,2).
Comparison of cytotoxic effect of Zinc Ferrite (zfo) nps and cobalt zinc ferrite on siha cells using MTT assay and neutral red assay
The cytotoxic effect of Zinc Ferrite (ZFO) and Cobalt Zinc Ferrite (CZFO) on uterine cancer cells (SiHa) were analyzed using MTT assay. Different concentrations (5, 10, 20, 50 µg/ml) of ZFO and CZFO were treated on the cells in culture. After 24 hours of treatment cell viability was measured. Our results showed that nanoparticles such as Zinc Ferrite (ZFO) and Cobalt Zinc Ferrite (CZFO) were didn’t show any significant change in the percentage viability of cells when compared to control in all the tested concentrations
Antiproliferative effect of ZFO and CZFO were further confirmed by neutral red assay. MTT assay rely on mitochondrial dehydrogenases, on the other hand neutral red assay is based on lysosomal dehydrogenase activity. Toxicity testing of nanoparticles in cancer cells, SiHa cells in culture was treated with different concentration of Zinc Ferrite (ZFO) and Cobalt Zinc Ferrite (CZFO) nanoparticles such as 5, 10, 20 and 50 µg/ml. After 24 hours of treatment cell viability was studied using Neutral Red assay. Our study showed that both Zinc Ferrite and Cobalt Zinc Ferrite didn’t show any significant change in cell viability at all the tested concentrations when compared to control (Figures 3,4).
Effect of Zinc Ferrite (zfo) Nps and cobalt zinc ferrite on h9c2 cell morphology
For studying the effect of ZFO and CZFO in normal cells, we selected rat embryonic cardio myoblast cells (H9c2 cells). An overnight treatment of Zinc Ferrite and Cobalt Zinc Ferrite (5, 10, 20 and 50 µg/ml) in H9c2 cells showed alterations in cell morphology. In ZFO treated cells, concentrations from the 20 µg/ml showed change in cell morphology (Figures 5,6).
Comparison of cytotoxic effect of Zinc Ferrite (ZFO) NPs and Cobalt Zinc Ferrite on H9c2 cells using MTT assay
The cytotoxic effect of Zinc Ferrite (ZFO) and Cobalt Zinc Ferrite (CZFO) on H9c2 cells were analyzed using MTT assay. Different concentrations (5, 10, 20, 50 µg/ml) of ZFO and CZFO were treated on the cells in culture. After 24 hours of treatment cell viability was measured by MTT assay. Our results showed that nanoparticles such as Zinc Ferrite (ZFO) and Cobalt Zinc Ferrite (CZFO) were didn’t show any significant change in the percentage viability of cells when compared to control in all the tested concentrations (Figure 7).
Comparative evaluation of cytotoxicity effect of Zinc Ferrite (ZFO) NPs and Cobalt Zinc Ferrite on HEK293 cells using MTT and neutral red assay
The cytotoxic effect of nanoparticles Zinc Ferrite (ZFO) and Cobalt Zinc Ferrite (CZFO) on normal cells were also studied using human embryonic kidney cells (HEK 293). Different concentration (5, 10, 20 and 50 µg/ml) of nanoparticles were treated on the cells in culture. After 24 hours of treatment cell morphology was observed. Cell viability was studied using MTT and Neutral Red assay. Our study indicated that Zinc Ferrite and Cobalt Zinc Ferrite didn’t show any significant change in cell viability of HEK 293 cells in all the tested concentrations (Figure 8).
Comparative effect of Zinc Ferrite (ZFO) NPs and Cobalt Zinc Ferrite (CZFO) NPs on Anti microbial activity
Anti-bacterial effect of Zinc Ferrite and Cobalt Zinc Ferrite was determined by well diffusion method. Wells are bored on the inoculated agar plate and different concentration (5, 10, 20 and 50 mg/ml) of both compounds were poured on the well. Both Gram negative (E.coli, S. marcescens and P. aeruginosa) and positive strains (B. subtilis and S. aureus) were used for the experiment. Serratia, Pseudomonas, Staphylococcus, Bacillus and E.coli showed no zone of inhibition on both nanoparticles. No zone of inhibition in E.coli, S.marcescens, S.aureus , B.subtilis and P.aeurginosa culture plates on treatment with Zinc Ferrite and Cobalt Zinc Ferrite. These results indicate the nanoparticles Zinc Ferrite and Cobalt Zinc Ferrite has no antibacterial effect against gram-positive and gram-negative strains (Figures 9-13).
Discussion
The death rate and the unwanted side effects of medicines are a serious concern. Most of the drugs have low bioavailability, solubility and side effects. By incorporation of functional hallmark capabilities conception that might be considered for development of drugs and treatment protocol design will be benefitted ad these all process is also supported by biochemical pathways. Hence, there is scope of specified co targeting of multiples cores, emerging capabilities of hallmark, enabling their characteristics in guiding mechanism combinations that provide durable and many effective targeted therapies for tumors in human population [27,28]. The hallmarks of tumor can be understood with time that these are considered as integral part of most of the types of cancers.
Nanotechnology based anticancer treatments are getting much attention now a days. Using nanoparticle carriers for these drugs will improved bioavailability, solubility and also help in the site specific release of drugs which will reduce the side effects. Here we selected ferrite nanoparticles such as Zinc ferrite and cobalt zinc ferrite for our study. Earlier reports showed that ferrite nanoparticles itself have anticancer property. Zinc ferrite and cobalt zinc ferrite nanoparticles have paramagnetic property [29,30].In the present study we evaluated the anticancer and antibacterial property of zinc ferrite and cobalt zinc ferrite nanoparticles. Cytotoxicity of zinc ferrite and cobalt zinc ferrite was tested on uterine cancer cells (SiHa) which didn’t show a significant cytotoxicity at 5, 10, 20 and 50µg/ml. This was evident from the results of neutral red assay and MTT assay. Treatment of H9c2 cells with zinc ferrite and cobalt zinc ferrite also showed the same result that the cell viability was not affected but cell morphology was altered at higher concentrations. The cytotoxic effect of Zinc ferrite and cobalt zinc ferrite was also analyzed in human embryonic kidney cells (HEK 293 cells).
All the tested concentrations didn’t affect the viability of HEK 293 cells. We also compared the antibacterial property of both ZFO and CZFO. Both compounds didn’t show antibacterial activity against both gram positive and negative bacteria. Previous studies showed that ferrite nanoparticles showed anticancer effect in various cancer cells [31,32]. Cobalt ferrite nanoparticles coated with hematoporphyrin and folic acid showed strong anticancer effect [33].Nickel Zinc nanoparticles nanoparticles also showed anticancer properties against human colon cancer HT29, breast cancer MCF7, and liver cancer HepG2 cells [34]. Study was planned based on these results but we couldn’t find cancer effect for Zinc ferrite and cobalt ferrite nanoparticles. As it doesn’t have any effect on tumor cells or normal cells, studies are needed to check its ability to act as drug carrier. Paramagnetic behavior of these compounds helps in concentrating the compounds in the affected area using external magnetic field [35] Here we took two compounds such as Zinc ferrite and cobalt zinc ferrite nanoparticles with magnetic property. Both nanocompounds didn’t show any cytotoxic effect on cancer cell or normal cell. Study on anti bacterial effect of these compounds also showed that there is no antibacterial effect for these compounds. As these compounds are not having any cytotoxicity, these can be used as drug carriers. Hence it is having magnetic property, using an external magnetic field these compounds can be concentrated to the site of inerest.
Declarations
Funding
The authors declare that no funds, grants, or other support were received during the preparation of this manuscript.
Conflict of interest
The authors declare that they have no known competing financial interests or personal relationships that could have appeared to influence the work reported in this paper
Data availability
Data generated or analyzed during this study are included in this article. The data are available from the author on reasonable request.
Ethical approval
This declaration is not applicable to this manuscript.
Author statement
Leena Grace: Conceptualization, Visualization, Supervision, Reviewing and editing the manuscript; Arya: Methodology, Data supplementation, Investigation, Writing and Original draft preparation
References
- Imran A, Qamar HY, Ali Q, Naeem H, Riaz M, Amin S, Kanwal N, Ali F, Sabar MF, Nasir IA. Role of Molecular Biology in Cancer Treatment: A Review Article. Iran J Public Health. 2017 Nov;46(11):1475-1485. PMID: 29167765; PMCID: PMC5696686.
- Jiang BH, Liu LZ. PI3K/PTEN signaling in angiogenesis and tumorigenesis. Adv Cancer Res. 2009;102:19-65. doi: 10.1016/S0065-230X(09)02002-8. PMID: 19595306; PMCID: PMC2933405.
- Kong G, Braun RD, Dewhirst MW. Characterization of the effect of hyperthermia on nanoparticle extravasation from tumor vasculature. Cancer Res. 2001 Apr 1;61(7):3027-32. PMID: 11306483.
- Boersma YL, Chao G, Steiner D, Wittrup KD, Plückthun A. Bispecific designed ankyrin repeat proteins (DARPins) targeting epidermal growth factor receptor inhibit A431 cell proliferation and receptor recycling. J Biol Chem. 2011 Dec 2;286(48):41273-41285. doi: 10.1074/jbc.M111.293266. Epub 2011 Oct 6. PMID: 21979953; PMCID: PMC3308840.
- Boyer SW, Schroeder AV, Smith-Berdan S, Forsberg EC. All hematopoietic cells develop from hematopoietic stem cells through Flk2/Flt3-positive progenitor cells. Cell Stem Cell. 2011 Jul 8;9(1):64-73. doi: 10.1016/j.stem.2011.04.021. PMID: 21726834; PMCID: PMC4103692.
- Brisson M, Drolet M. Global elimination of cervical cancer as a public health problem. Lancet Oncol. 2019 Mar;20(3):319-321. doi: 10.1016/S1470-2045(19)30072-5. Epub 2019 Feb 19. PMID: 30795952.
- Cagle PT, Allen TC, Olsen RJ. Lung cancer biomarkers: present status and future developments. Arch Pathol Lab Med. 2013 Sep;137(9):1191-8. doi: 10.5858/arpa.2013-0319-CR. PMID: 23991729.
- Cakir BÖ, Adamson P, Cingi C. Epidemiology and economic burden of nonmelanoma skin cancer. Facial Plast Surg Clin North Am. 2012 Nov;20(4):419-22. doi: 10.1016/j.fsc.2012.07.004. PMID: 23084294.
- Cavallaro U, Christofori G. Cell adhesion and signalling by cadherins and Ig-CAMs in cancer. Nat Rev Cancer. 2004 Feb;4(2):118-32. doi: 10.1038/nrc1276. PMID: 14964308.
- Chauhan VP, Chen IX, Tong R, Ng MR, Martin JD, Naxerova K, Wu MW, Huang P, Boucher Y, Kohane DS, Langer R, Jain RK. Reprogramming the microenvironment with tumor-selective angiotensin blockers enhances cancer immunotherapy. Proc Natl Acad Sci U S A. 2019 May 28;116(22):10674-10680. doi: 10.1073/pnas.1819889116. Epub 2019 Apr 30. PMID: 31040208; PMCID: PMC6561160.
- Cheng N, Chytil A, Shyr Y, Joly A, Moses HL. Transforming growth factor-beta signaling-deficient fibroblasts enhance hepatocyte growth factor signaling in mammary carcinoma cells to promote scattering and invasion. Mol Cancer Res. 2008 Oct;6(10):1521-33. doi: 10.1158/1541-7786.MCR-07-2203. PMID: 18922968; PMCID: PMC2740918.
- Deshpande A, Sicinski P, Hinds PW. Cyclins and cdks in development and cancer: a perspective. Oncogene. 2005 Apr 18;24(17):2909-15. doi: 10.1038/sj.onc.1208618. PMID: 15838524.
- Esfandiarpour-Boroujeni S, Bagheri-Khoulenjani S, Mirzadeh H, Amanpour S. Fabrication and study of curcumin loaded nanoparticles based on folate-chitosan for breast cancer therapy application. Carbohydr Polym. 2017 Jul 15;168:14-21. doi: 10.1016/j.carbpol.2017.03.031. Epub 2017 Mar 10. PMID: 28457434.
- Grace BL. Antibacterial assessment of cuttlebone. Biomed J Sci & Tech Res 2022;47(4):007530. doi: 10.26717/BJSTR.2022.47.007530.
- Grasset F, Labhsetwar N, Li D, Park DC, Saito N, Haneda H, Cador O, Roisnel T, Mornet S, Duguet E, Portier J. Synthesis and magnetic characterization of zinc ferrite nanoparticles with different environments: powder, colloidal solution, and zinc ferrite− silica core− shell nanoparticles. Langmuir. 2002 Oct 15; 18 (21):8209-16. doi: 10.1021/la020322b.
- Greenman C, Stephens P, Smith R, Dalgliesh GL, Hunter C, Bignell G, Davies H, Teague J, Butler A, Stevens C, Edkins S, O'Meara S, Vastrik I, Schmidt EE, Avis T, Barthorpe S, Bhamra G, Buck G, Choudhury B, Clements J, Cole J, Dicks E, Forbes S, Gray K, Halliday K, Harrison R, Hills K, Hinton J, Jenkinson A, Jones D, Menzies A, Mironenko T, Perry J, Raine K, Richardson D, Shepherd R, Small A, Tofts C, Varian J, Webb T, West S, Widaa S, Yates A, Cahill DP, Louis DN, Goldstraw P, Nicholson AG, Brasseur F, Looijenga L, Weber BL, Chiew YE, DeFazio A, Greaves MF, Green AR, Campbell P, Birney E, Easton DF, Chenevix-Trench G, Tan MH, Khoo SK, Teh BT, Yuen ST, Leung SY, Wooster R, Futreal PA, Stratton MR. Patterns of somatic mutation in human cancer genomes. Nature. 2007 Mar 8;446(7132):153-8. doi: 10.1038/nature05610. PMID: 17344846; PMCID: PMC2712719.
- Hartgrink HH, Jansen EP, van Grieken NC, van de Velde CJ. Gastric cancer. Lancet. 2009 Aug 8;374(9688):477-90. doi: 10.1016/S0140-6736(09)60617-6. Epub 2009 Jul 20. PMID: 19625077; PMCID: PMC4613761.
- Lee J, Xiao YY, Sun YY, Balderacchi J, Clark B, Desani J, Kumar V, Saverimuthu A, Win KT, Huang Y, Xu Y. Prevalence and characteristics of hereditary non-polyposis colorectal cancer (HNPCC) syndrome in immigrant Asian colorectal cancer patients. BMC Cancer. 2017 Dec 13;17(1):843. doi: 10.1186/s12885-017-3799-y. PMID: 29237405; PMCID: PMC5729240.
- Lemmon MA, Schlessinger J. Cell signaling by receptor tyrosine kinases. Cell. 2010 Jun 25;141(7):1117-34. doi: 10.1016/j.cell.2010.06.011. PMID: 20602996; PMCID: PMC2914105.
- Li L, Tong R, Li M, Kohane DS. Self-assembled gemcitabine-gadolinium nanoparticles for magnetic resonance imaging and cancer therapy. Acta Biomater. 2016 Mar;33:34-9. doi: 10.1016/j.actbio.2016.01.039. Epub 2016 Jan 27. PMID: 26826531; PMCID: PMC4777675.
- Lowe SW, Cepero E, Evan G. Intrinsic tumour suppression. Nature. 2004 Nov 18;432(7015):307-15. doi: 10.1038/nature03098. PMID: 15549092.
- Maheswaran S, Haber DA. Circulating tumor cells: a window into cancer biology and metastasis. Curr Opin Genet Dev. 2010 Feb;20(1):96-9. doi: 10.1016/j.gde.2009.12.002. Epub 2010 Jan 12. PMID: 20071161; PMCID: PMC2846729.
- Mornet S, Vasseur S, Grasset F, Duguet E. Magnetic nanoparticle design for medical diagnosis and therapy. Journal of materials chemistry. 2004;14(14):2161-75. doi: 10.1039/B402025A.
- Mundekkad D, Cho WC. Nanoparticles in Clinical Translation for Cancer Therapy. Int J Mol Sci. 2022 Feb 1;23(3):1685. doi: 10.3390/ijms23031685. PMID: 35163607; PMCID: PMC8835852.
- Nigam A, Saini S, Singh B, Rai AK, Pawar SJ. Zinc doped magnesium ferrite nanoparticles for evaluation of biological properties viz antimicrobial, biocompatibility, and in vitro cytotoxicity. Materials Today Communications. 2022; 31:103632. doi: 10.1016/j.mtcomm.2022.103632.
- Oliver SA, Harris VG, Hamdeh HH, Ho JC. Large zinc cation occupancy of octahedral sites in mechanically activated zinc ferrite powders. Applied Physics Letters. 2000;76(19):2761-3. doi:10.1063/1.126467.
- Park BJ, Choi KH, Nam KC, Ali A, Min JE, Son H, Uhm HS, Kim HJ, Jung JS, Choi EH. Photodynamic Anticancer Activities of Multifunctional Cobalt Ferrite Nanoparticles in Various Cancer Cells. J Biomed Nanotechnol. 2015 Feb;11(2):226-35. doi: 10.1166/jbn.2015.2031. PMID: 26349298.
- Park EJ, Yi J, Chung KH, Ryu DY, Choi J, Park K. Oxidative stress and apoptosis induced by titanium dioxide nanoparticles in cultured BEAS-2B cells. Toxicol Lett. 2008 Aug 28;180(3):222-9. doi: 10.1016/j.toxlet.2008.06.869. Epub 2008 Jul 10. PMID: 18662754.
- Porkka N, Lahtinen L, Ahtiainen M, Böhm JP, Kuopio T, Eldfors S, Mecklin JP, Seppälä TT, Peltomäki P. Epidemiological, clinical and molecular characterization of Lynch-like syndrome: A population-based study. Int J Cancer. 2019 Jul 1;145(1):87-98. doi: 10.1002/ijc.32085. Epub 2019 Jan 7. PMID: 30575961.
- Sarala, E. &Naik, M. &Vinuth, & Reddy, Y. &Sujatha, H. Green synthesis of Lawsoniainermis-mediated zinc ferrite nanoparticles for magnetic studies and anticancer activity against breast cancer (MCF-7) cell lines. Journal of Materials Science: Materials in Electronics. 2020;31(3):1-8. doi: 10.1007/s10854-020-03394-8.
- Tanaka K, Makita M, Shimizugawa Y, Hirao K, Soga N. Structure and high magnetization of rapidly quenched zinc ferrite. Journal of Physics and Chemistry of Solids. 1998;59(9):1611-8. doi: 10.1016/S0022-3697(98)00078-X.
- Tong R, Kohane DS. New Strategies in Cancer Nanomedicine. Annu Rev Pharmacol Toxicol. 2016;56:41-57. doi: 10.1146/annurev-pharmtox-010715-103456. Epub 2015 Oct 28. PMID: 26514197.
- Sun S, Wang YH, Gao X, Wang HY, Zhang L, Wang N, Li CM, Xiong SQ. Current perspectives and trends in nanoparticle drug delivery systems in breast cancer: bibliometric analysis and review. Front Bioeng Biotechnol. 2023 Sep 12;11:1253048. doi: 10.3389/fbioe.2023.1253048. PMID: 37771575; PMCID: PMC10523396.
- Shenoy SD, Joy PA, Anantharaman MR. Effect of mechanical milling on the structural, magnetic and dielectric properties of co-precipitated ultrafine zinc ferrite. Journal of magnetism and magnetic materials. 2004;269(2):217-26. doi: 10.1016/S0304-8853(03)00596-1.
- Talmadge JE, Fidler IJ. AACR centennial series: the biology of cancer metastasis: historical perspective. Cancer Res. 2010 Jul 15;70(14):5649-69. doi: 10.1158/0008-5472.CAN-10-1040. Epub 2010 Jul 7. PMID: 20610625; PMCID: PMC4037932.
Content Alerts
SignUp to our
Content alerts.
 This work is licensed under a Creative Commons Attribution 4.0 International License.
This work is licensed under a Creative Commons Attribution 4.0 International License.